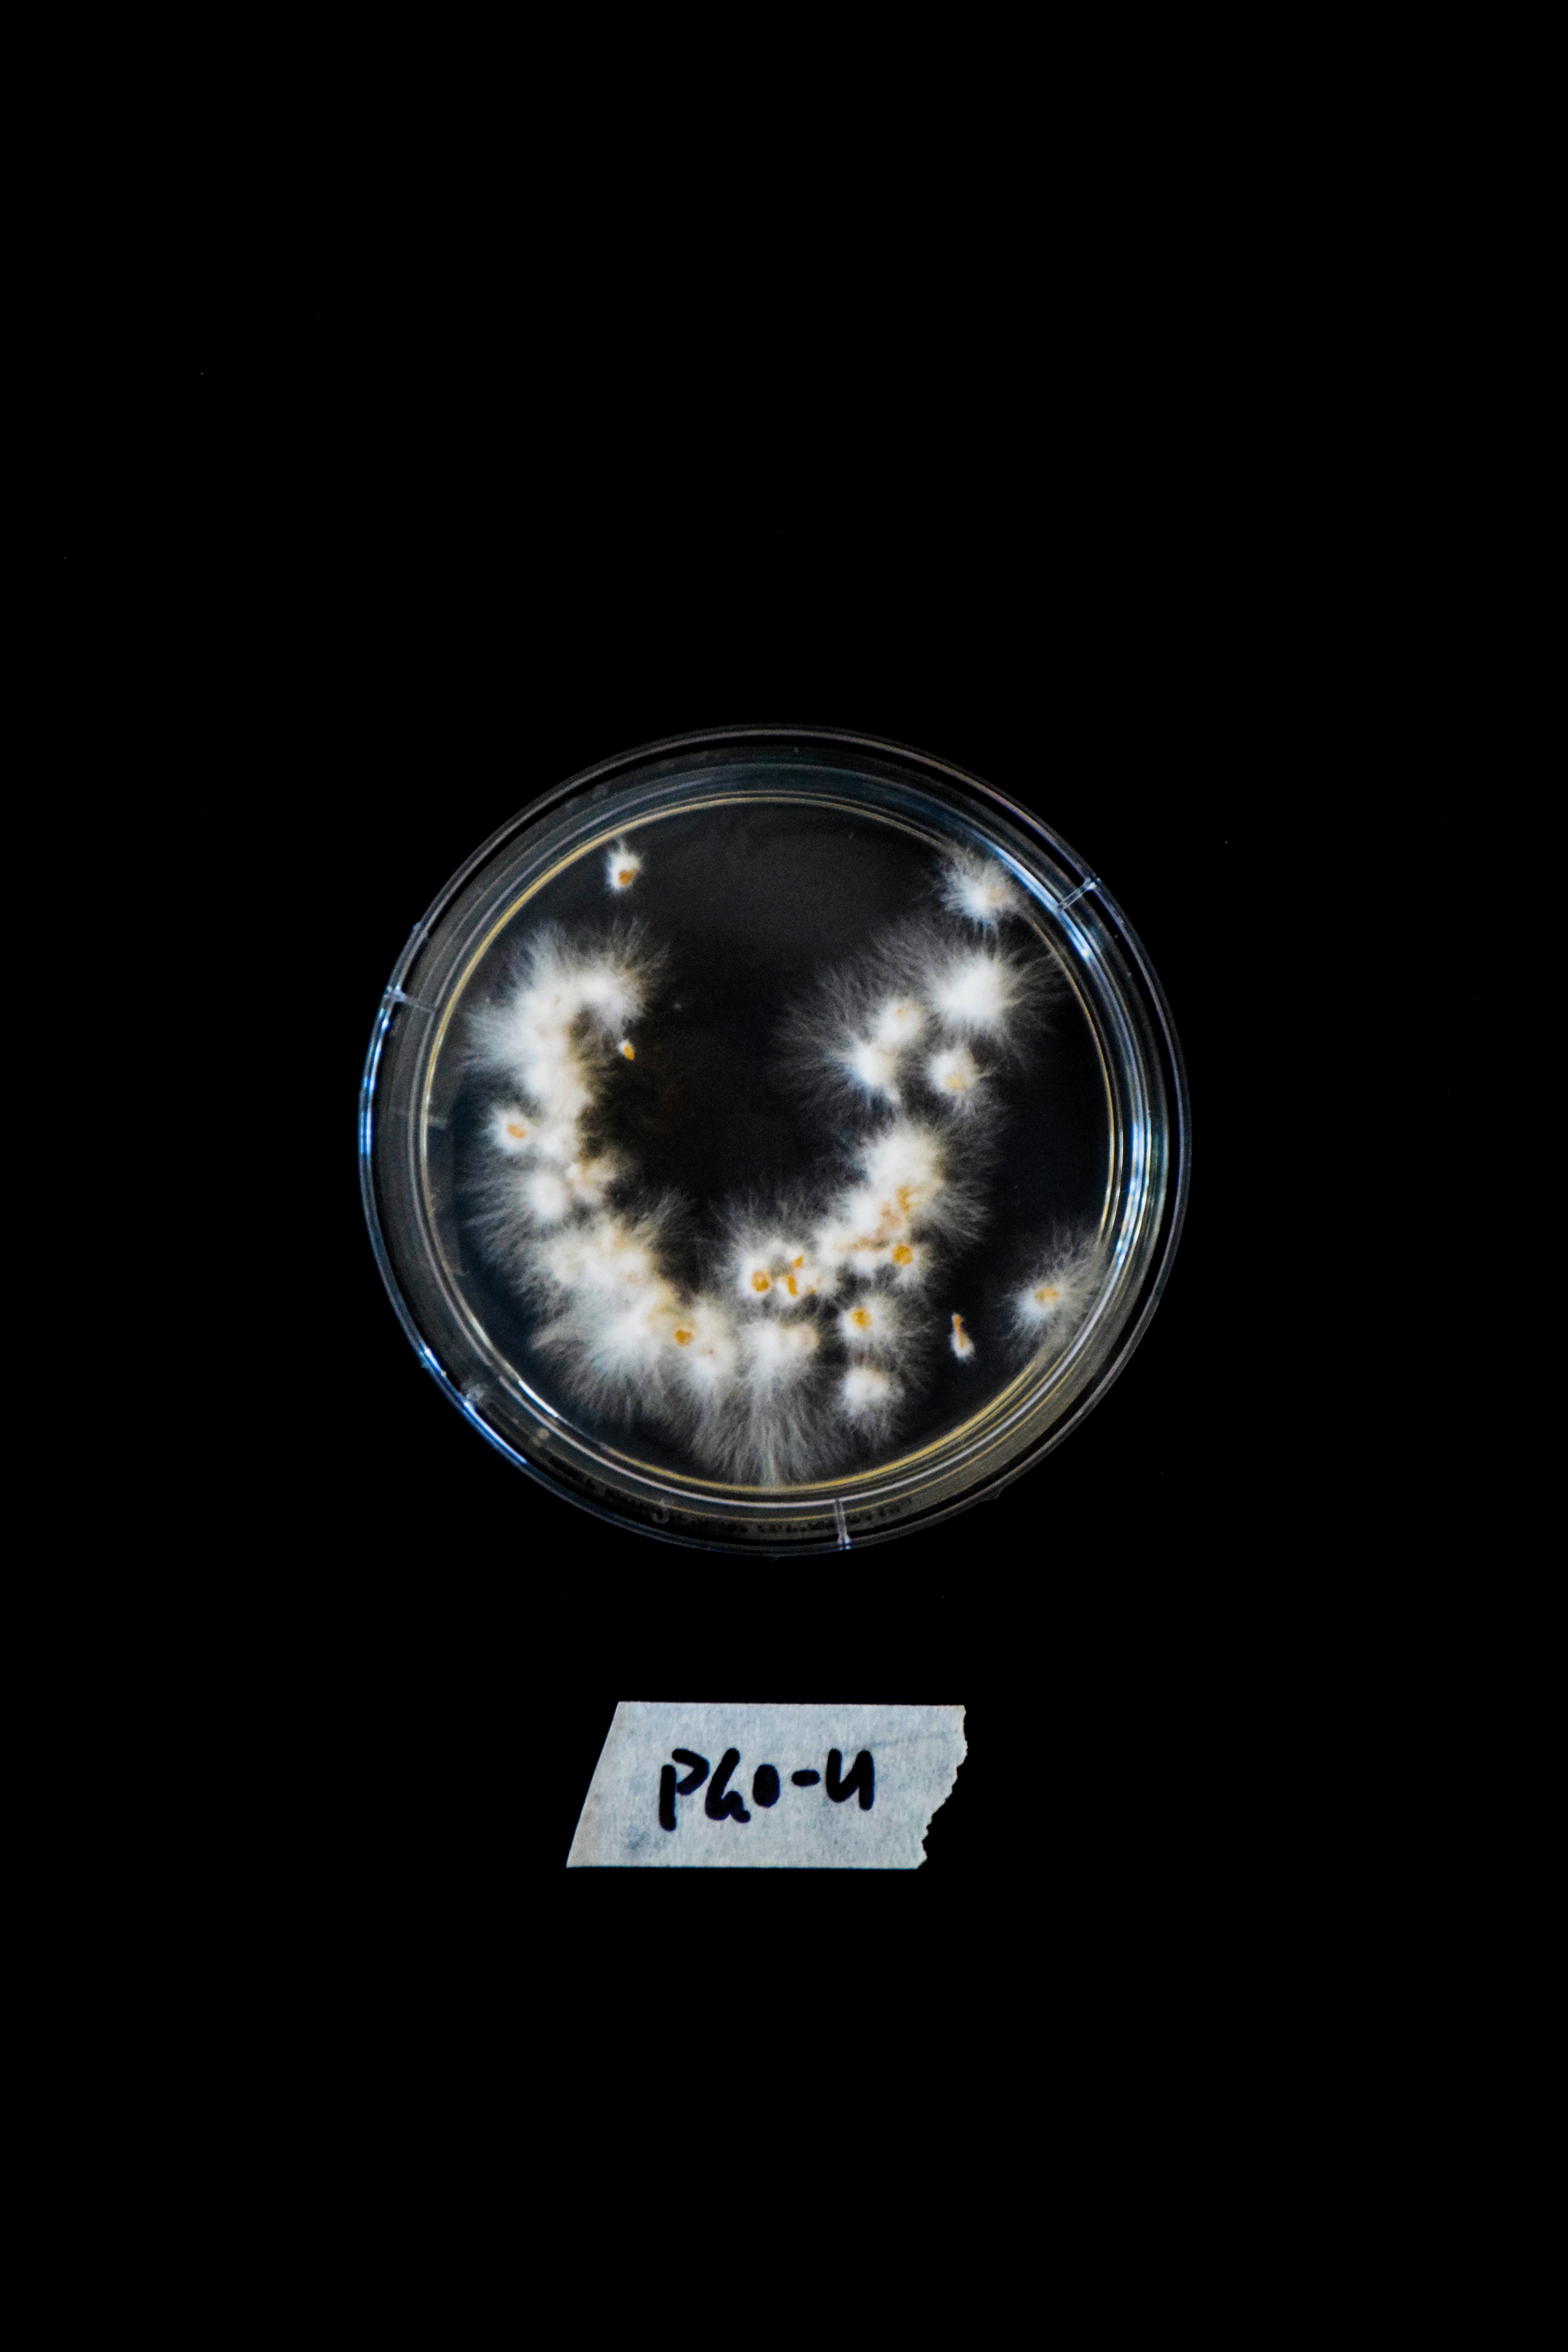
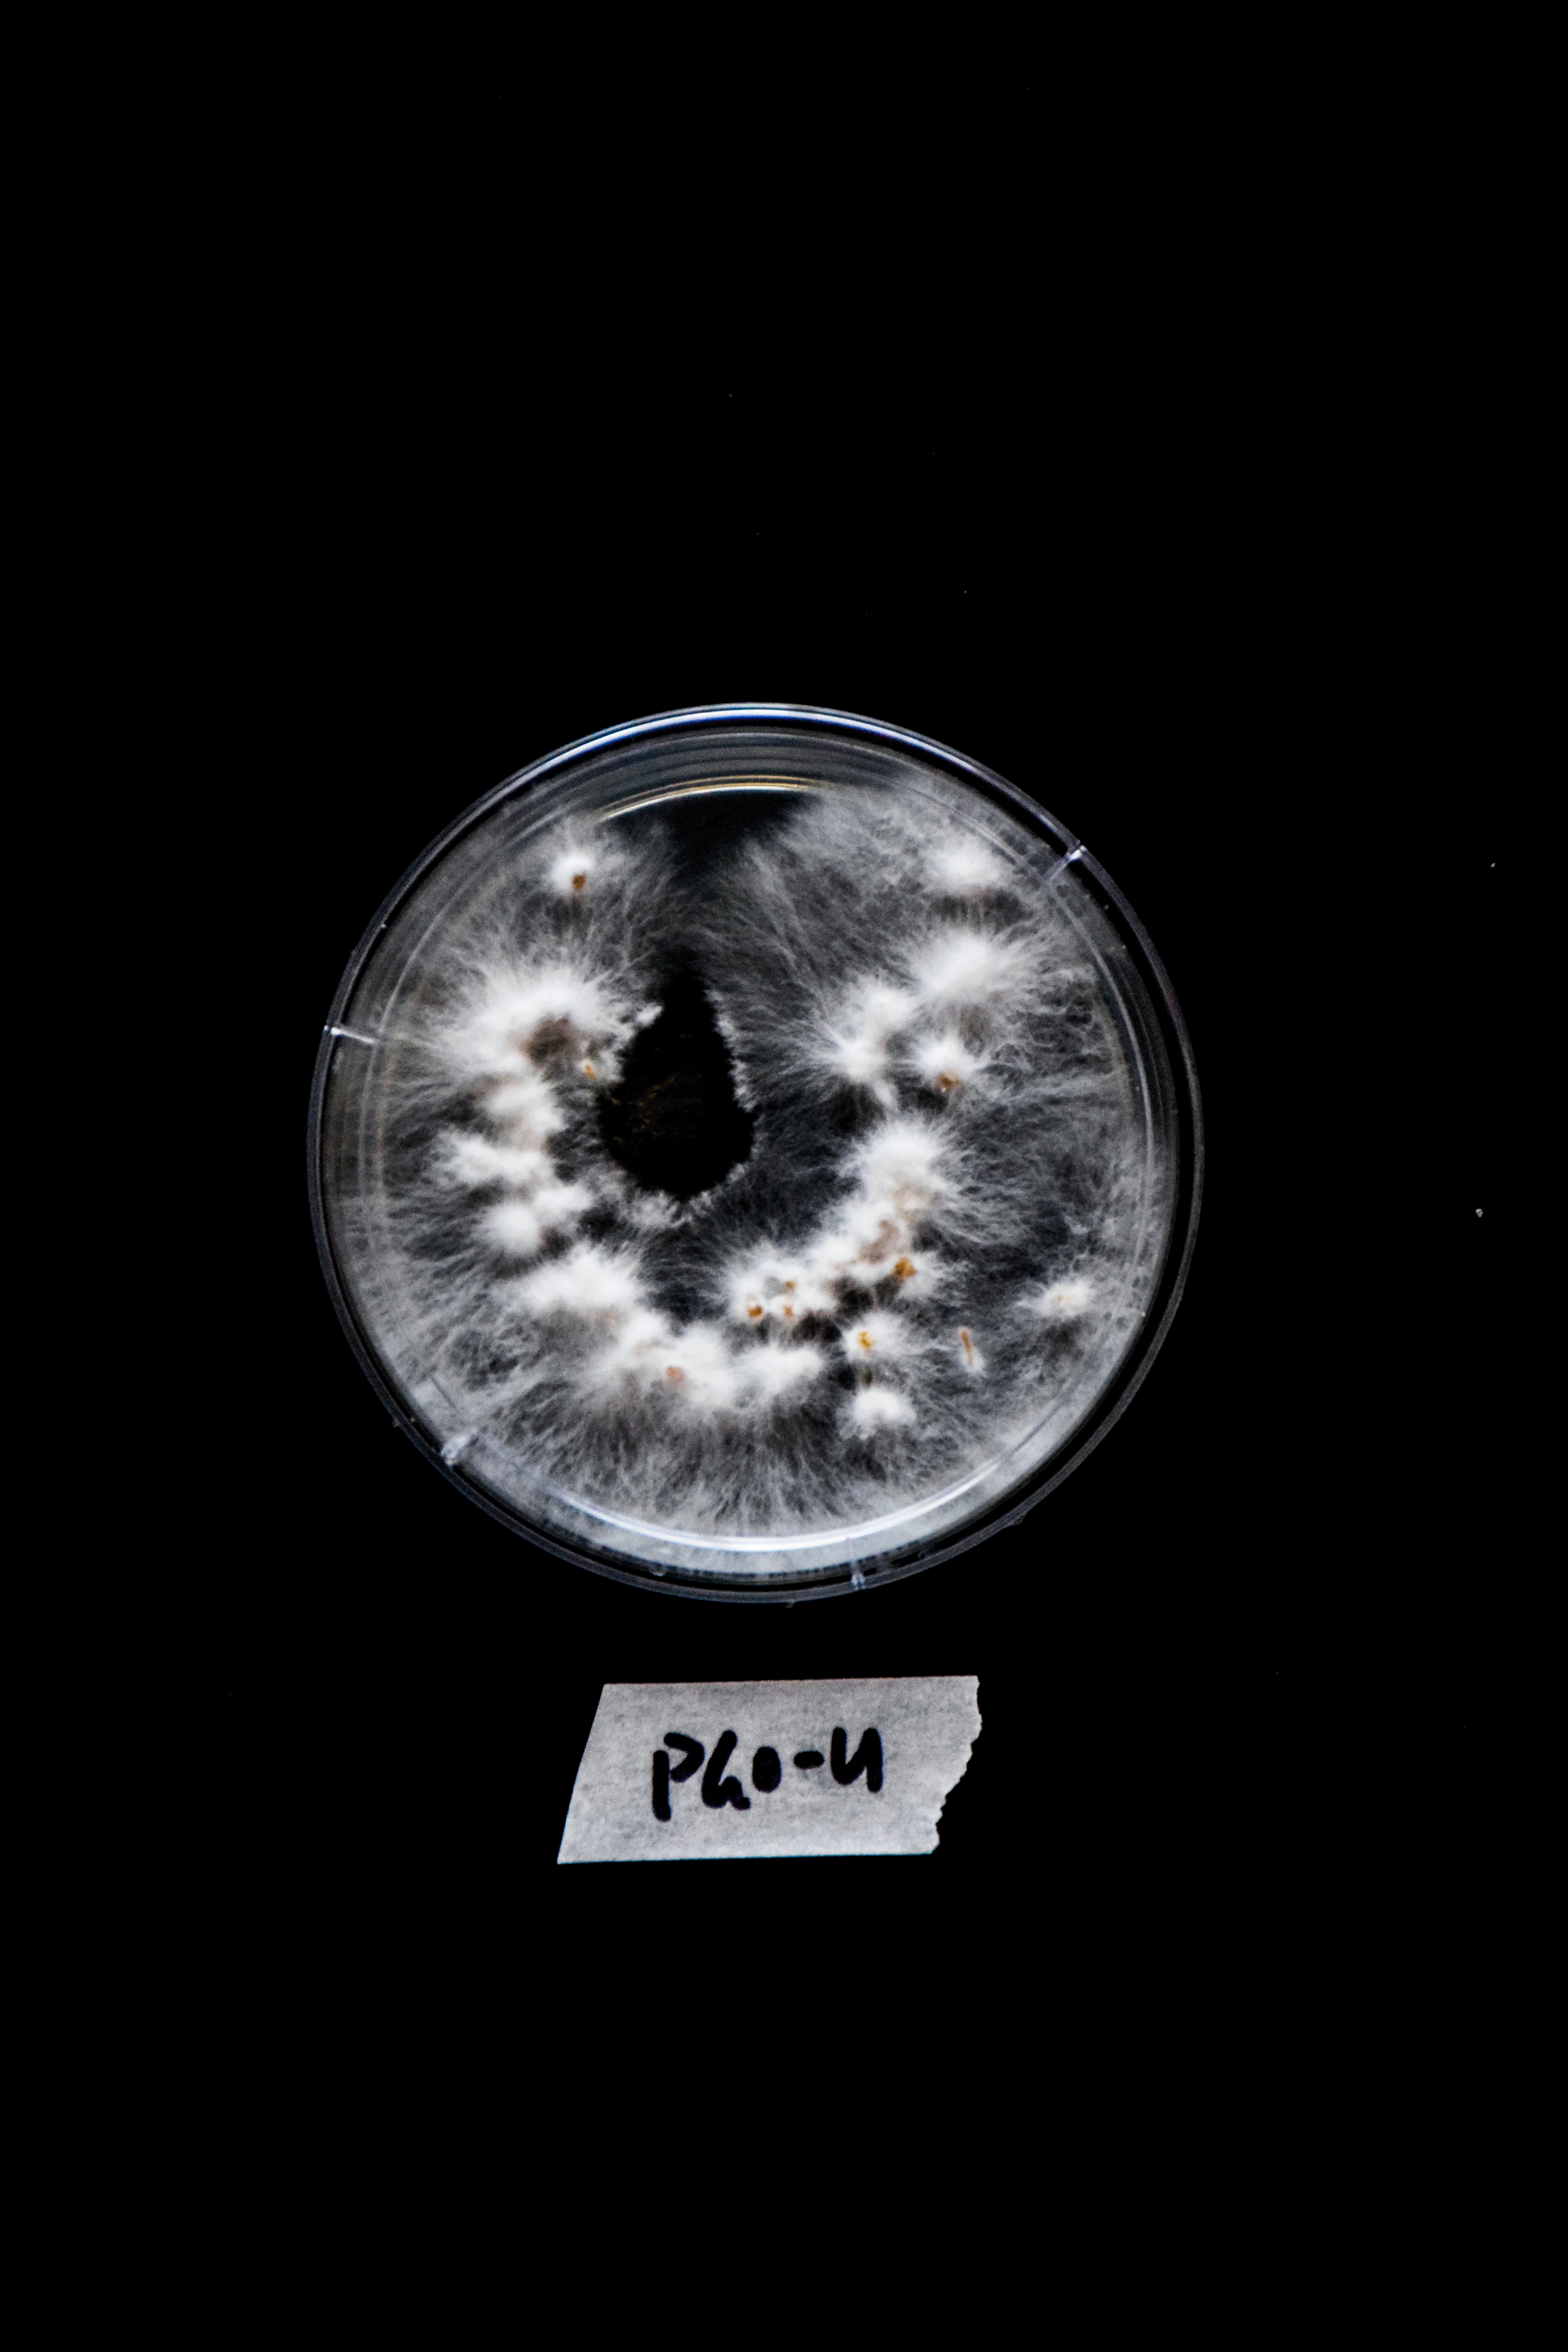

Experiment Log 1B
1B. Mycelium Cultivation Typography
CONTINUED AIM:
This experiment sought to expand on the Experiment 1A, and explore how a more randomised placement of the letters on the petri dishes might produce alternative outcomes and growths. By developing another similar experiment with at least one changed variable, the outcomes of both these experiments will be compared to analyse how these variables have influenced the growths.
Comparison of the letter T (PGO) DAY 7 growth for Experiment 1A vs Experiment 1B

METHODS:
Refer to Experiment 1A’s process.
However, the placement of the grain spawn was randomised by scattering by hand but I attempted to maintain the general formation of each letter of the alphabet.
Comparison of the placement of the letter H from Experiment 1A and 1B


OBSERVATIONS:
As this experiment was executed after Experiment 1A, several variables including the placement of the grain spawn were completely different. As this experiment was done in my home, the environment and weather conditions were completely uncontrolled. Temperatures were changing every day, and as the peak of spring was coming up, warmer temperatures were becoming more common. This would have significantly influenced the growth of the mycelium.
However, like Experiment 1A, the PGO species grew much faster than Reishi. On Day 5, Reishi was only starting to show its visible growth, whilst PGO had already started growing clusters of mycelium. Some letters like S, T and U (PGO) had significantly grown large areas of grouped fluffy mycelium. On the other hand, other PGO letters that had begun on the same day had much less growth. As the letters S, T and U were in the same shoebox; and although each shoebox was placed directly next to each other, the temperature or sunlight may have been stronger on certain shoeboxes to influence their growth.
Growth of the letter N (Reishi) on DAY 1, 5 and 7



Growth of the letter U (PGO) on DAY 1, 5 and 7

Mycelium Alphabet on DAY 7

Interestingly, the random placement of the grain spawn seemed to enhance the growth of mycelium. It seemed as the spawn was more spread out and covered more surface area across the petri dish, each hyphae making up the mycelium network was able to connect with more hyphae. Therefore the expansion of the letters in this experiment was much greater than Experiment 1A.
From these observations, I made a comparative catalogue to view the difference in the growths of Experiment 1A and 1B easily. This catalogue shows the comparisons for each letter of the alphabet from Day 1 and Day 7.
Comparative Catalogue of Mycelium Cultivated Typography
REFLECTION:
The key observations from this experiment were the unpredictable nature of mycelium, no matter how controlled each variable would be. Even if the environment, conditions, and placement of each grain spawn was controlled and the same every time the experiment was conducted, the final growth would always be different. Ultimately, the amount of growth and direction of the mycelium could never be controlled.
Evidently, if the variables were all changed, the final growth and form of each mycelium letter would be seemingly endless. This incited my curiosity for the possibilities of using these properties of unpredictable mycelium growth creating endless versions of different forms and shapes to develop a generative typeface that could produce infinite typefaces.
DESIGN RESPONSE:
This reflection inspired a design concept for a generative typeface that emulates the unpredictable nature of mycelium growth, generating an array of mycelium formations. This generative typeface would create a new typeface everytime the process was repeated, like how the mycelium would grow differently in every experiment. I explored this idea by starting with an existing typeface to use as a base structure for growing this new mycelium typeface.
I documented the mycelium growth in Experiment 1A and 1B in a Comparative Catalogue, visually comparing the growth of each letter from Day 1 to Day 7. This catalogue was then used as a visual reference to inspire mutations or the placement of new elements, shapes and features onto the base typeface. Unexpected variables like bacteria could also be included in this stage of adding or changing the structure of the base typeface.
This process enables the generation of a new typeface each time a different reference is used from the Comparative Catalogue, as the mycelium growth will always be different in each experiment and letter. This process is explained in depth in the brochure below.
The process of cultivating my own mycelium typeface


As described in the brochure above, I tested this design concept using one letter (R) from the alphabet to determine if I was able to successfully create a new typeface. The outcomes of this experiment revealed that I was reasonably successful in creating a new form for the letter. As I only trialled this proposed concept for one letter, I am unable to make a thorough judgement on the success of creating a whole typeface, as a typeface typically consists of all the letters, numbers and symbols. Therefore, it is recommended to extend this experiment to cover the entire alphabet and reevaluate its success.
Nonetheless, from the results produced to date, I concluded that the idea of a generative typeface system was successful in creating new typefaces. This process allowed me to quickly create new and unique letterforms using an existing precedent (the Comparative Catalogue) as a visual guide.
Guides help visualise or represent ideas or themes that could be difficult to see or comprehend. For many designers, thinking or confirming a concept is probably the most challenging stage before being able to design. Using a guide, like the Comparative Catalogue, initiates this process and allows the designer to then input their own styles, rules and aesthetics into the development of the typeface. Typically guides have limitations such as lack of details or accuracy. However, in this case, these limitations aid the design process. Instead, it allows for more freedom and creativity to be included during the development and iteration stages of the typeface. This Comparative Catalogue reflects the natural processes of mycelium growth, and by using it as a guide, designers can create various organic typefaces.
During these experiments, a more-than-human perspective was incorporated through collaboration with non-humans - the mycelium. The mycelium grew along the paths I had formed using the grain spawn and created various unpredictable forms. The organic shapes created from this experiment are unique to the features and growth of mycelium and may not have the same with a human-centred approach. Working and thinking with non-humans allows us to think beyond the established human boundaries for designing and solving problems we may not be able to resolve by only thinking from a human-centred perspective.